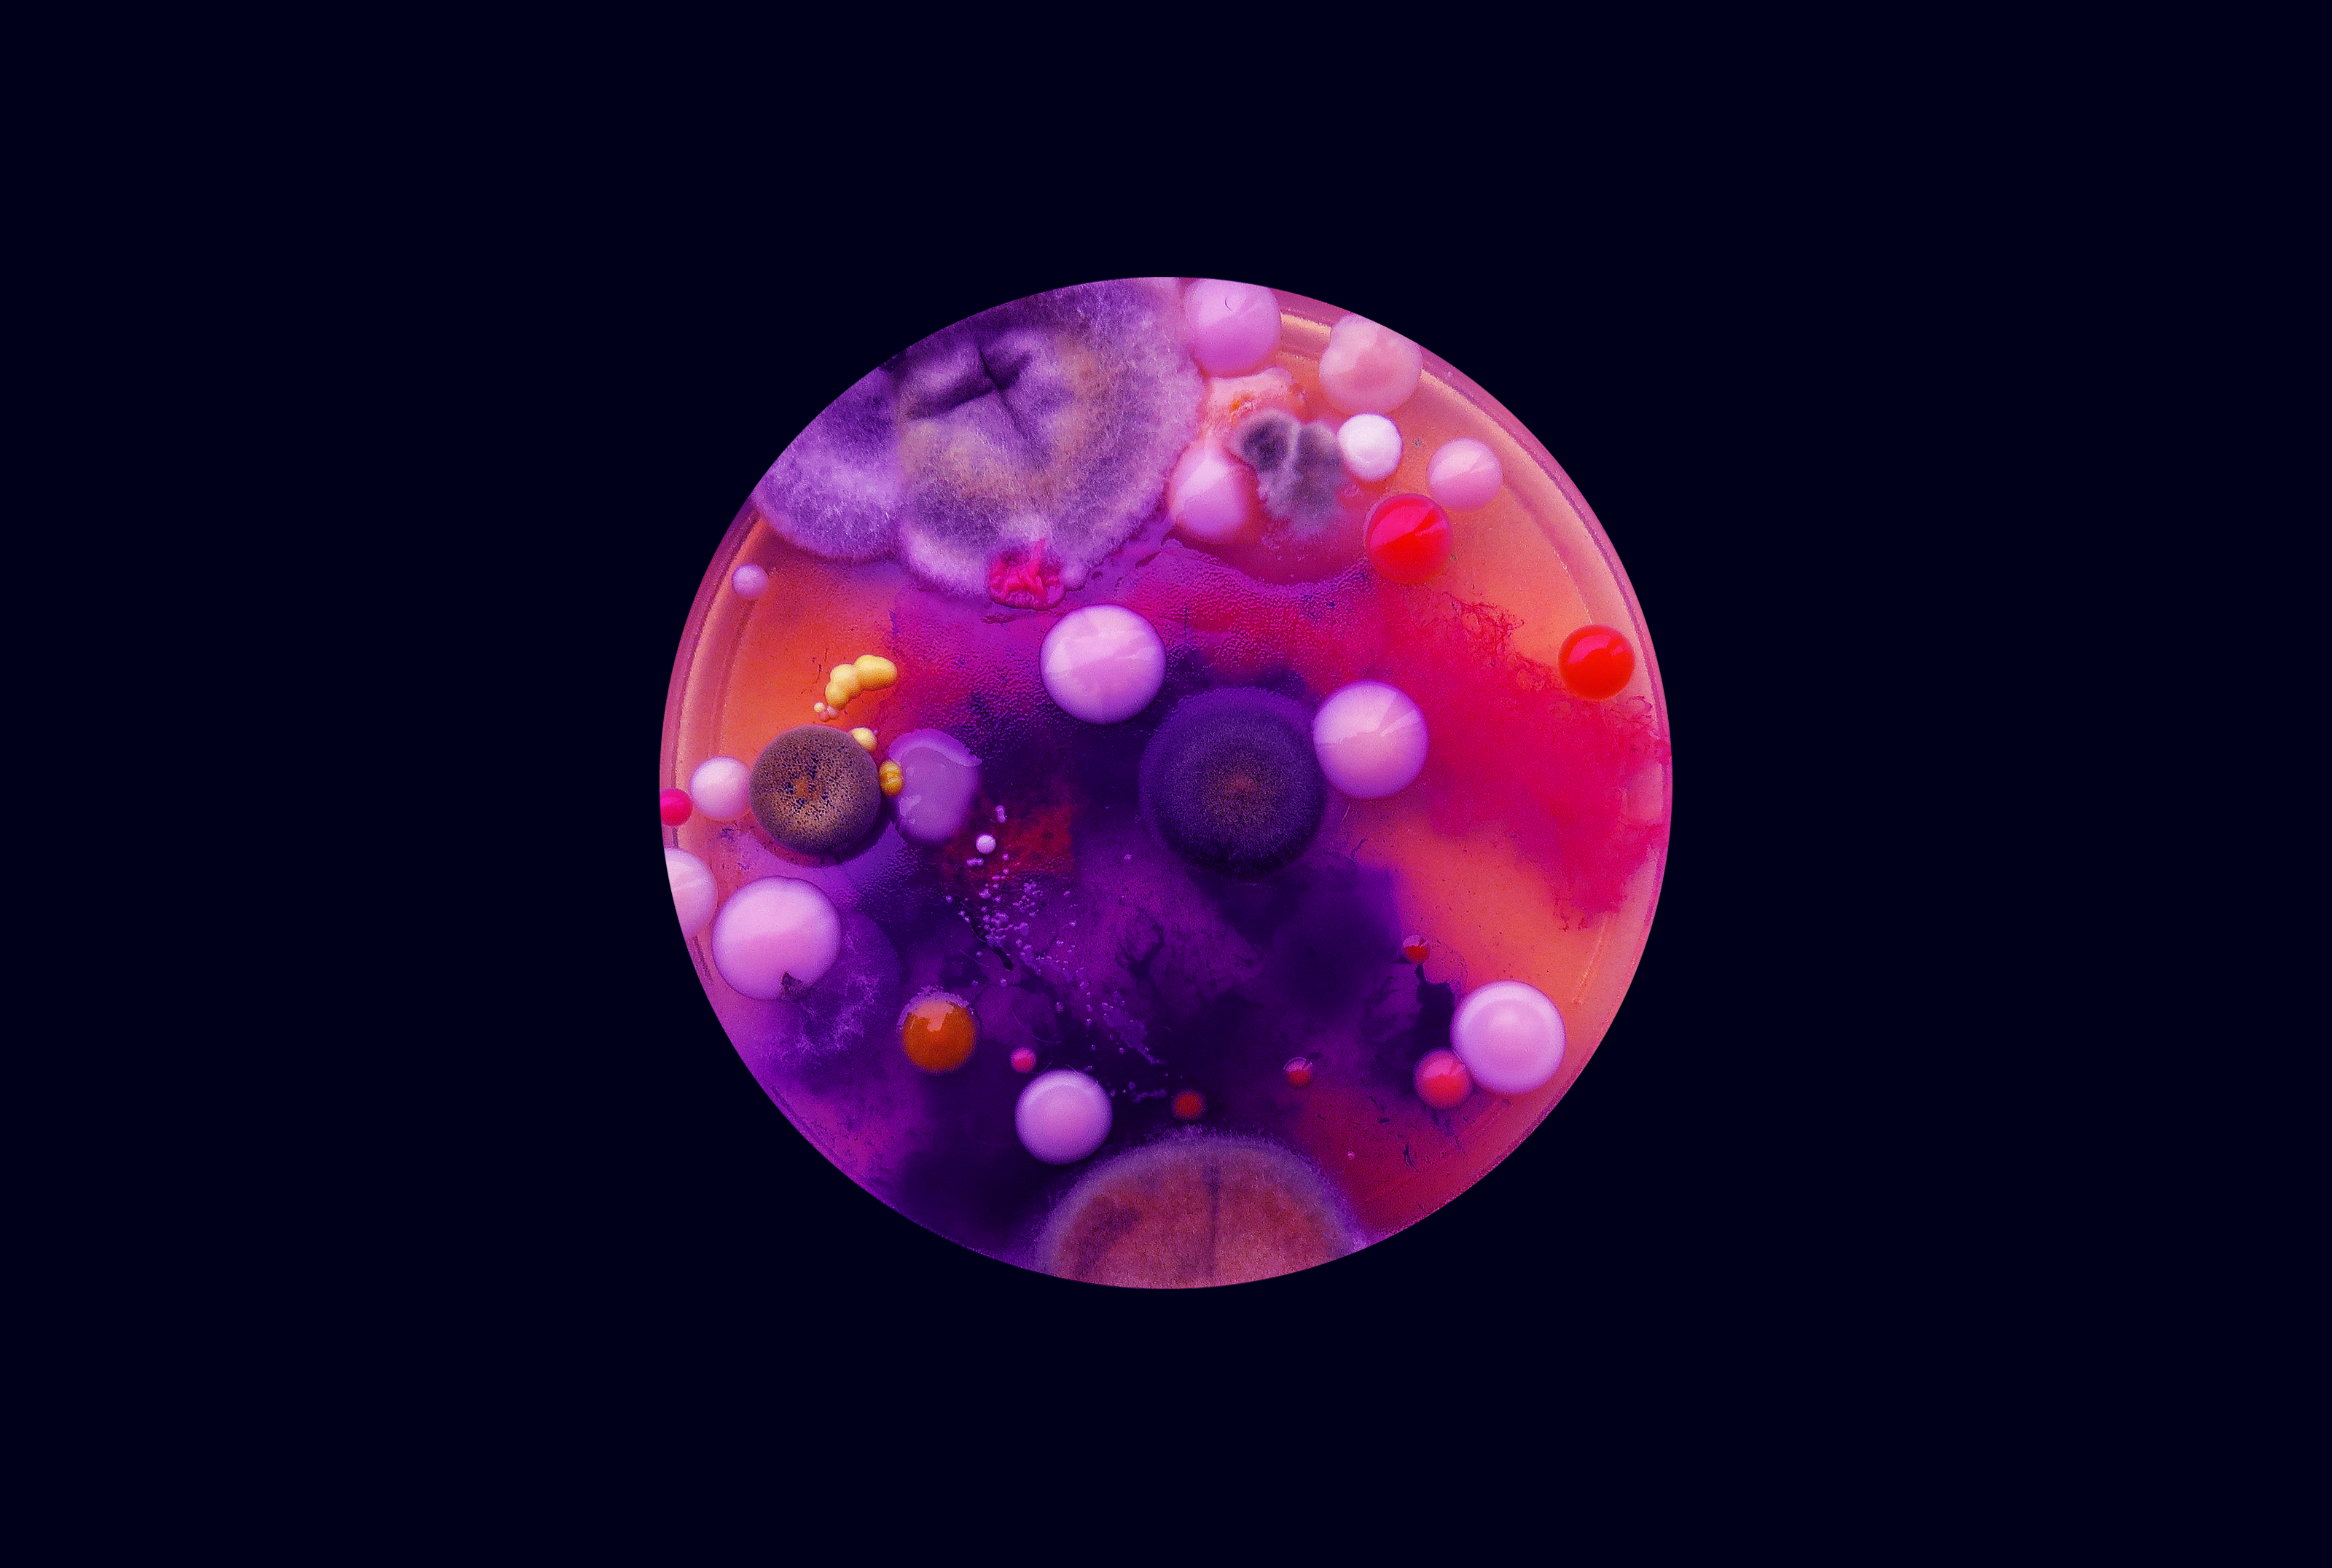

Время, когда цифровое становится более хрупким.
Синергия между грибковыми телами и неорганической формой присутствия.
Соблазнительные текстуры воплотились в нечеловеческое существо, изображающее новую версию Матери-природы.








Спасибо за просмотр!



Время, когда цифровое становится более хрупким.
Синергия между грибковыми телами и неорганической формой присутствия.
Соблазнительные текстуры воплотились в нечеловеческое существо, изображающее новую версию Матери-природы.

Спасибо за просмотр!
